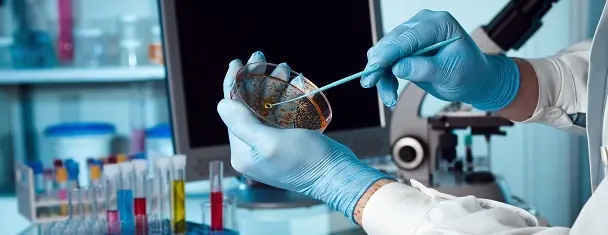
Furano: Sustancia Cancerígena en tus Alimentos

dnlctv
Usuario (Chile)

Panda gigante fingió embarazo para recibir mejor alimentación y arruinó transmisión mundial al fingir embarazo. Expertos señalan que los embarazos "fantasmas" son comunes en esta especie. El nacimiento de los pequeños pandas iba a ser transmitido en vivo en China. Durante las últimas semanas, los encargados de un centro de cría de pandas gigantes en China pensaron que Ai Hin daría a luz por estos días. De hecho, el nacimiento de los esperados cachorros sería transmitido en vivo por primera vez a través de la televisión, un evento que fue altamente publicitado. Sin embargo, el centro debió suspender todos los preparativos, al detectar que la osa panda gigante no estaba realmente preñada, pues había vivido un "embarazo fantasma", algo común en esta especie, según expertos. Wu Kongju, especialista del centro, dijo al periódico Xinhua, que al recibir mejor atención, algunos pandas continúan mostrando un comportamiento de embarazada, mejorando su calidad de vida. Ai Hin comenzó a mostrar signos de estar esperando crías el mes pasado, algo que en esta especie se nota por cambios hormonales y en su comportamiento, como mayor somnolencia, modificación en el apetito y menor movilidad. Desde ese momento fue trasladada a una habitación individual con aire acondicionado, atención durante las 24 horas, y una alimentación especial que incluye bambú y frutas. Los especiales cuidados que reciben las hembras preñadas se debe a que cada cachorro es importante para la preservación de los pandas, que están al borde de la extinción. Actulamente existen unos 1.600 en libertad, sobre todo en las montañas de Sichuan, y otros 300 son cuidados en cautiverio. Ai Hin mostraba signos de embarazo, pero simplemente lo hizo para conseguir más comida. En el momento de la transmisión del nacimiento, no se pudo hacer nada: No había cachorro. A los expertos no les sorprende esto, informa la agencia Xinhua. "Cuando los pandas están en este estado reciben más comida, pero algunos pandas lo usan para recibir mejores condiciones de vida", afirmó el especialista Wu Kongju, consultado por la agencia. Este también explicó que el embarazo psicológico es común en animales en vías de xtinción. Ai esta en el Centro de Investigación Chengdu. Comenzó a tener menos apetito, y menos movilidad, por lo que de inmediato la movieron a una habitación especial. Por ahora, ha vuelto a sus condiciones de antes. Es de remarcar que solo el 24% de las pandas quedan embarazadas, por lo que de ellas depende la supervivencia de la especie.

Alivio físico, mejor circulación sanguínea, disminución del riesgo de eyaculación sanguínea… El 90 % de hombres se masturba regularmente y ¡a todos les sienta bien! Alivio físico, mejor circulación sanguínea, disminución del riesgo de eyaculación sanguínea... La masturbación es buena para la salud, pero sobre todo, aporta gran placer. Ideas preconcebidas Nuestros antepasados aseguraban que la masturbación causaba sordera, ceguera, que reducía el tamaño del pene... Y todo para disuadir a los hombres de esta práctica. Según ellos, masturbarse reducía la capacidad de reproducción porque se malgastaba el semen ya que creían que era limitado. Tranquilos: todos esos mitos son mentira. El 90 % de hombres se masturba regularmente y ¡a todos les sienta bien! ¿Necesidad física o placer? No te sorprendas si le pillas de pleno en la ducha: no significa que estés frustrado. El hombre se masturba no sólo para llegar al orgasmo y liberar las tensiones sexuales: se trata además de una necesidad física. Los orgasmos sexuales producen y acumulan esperma. Al cabo de unos días, le cuerpo tiene que expulsar ese esperma acumulado para dejar sitio al “fresco”. Eyaculación La manera en que se masturbe tiene consecuencias directas en su sexualidad. Una masturbación demasiado rápida genera a menudo problemas de eyaculación precoz. Así que nada de precipitarse. Desde la adolescencia, el hombre tiene que tomarse su tiempo para descubrir su cuerpo para asegurar un control mayor de la eyaculación. Cuando se prueba, mejora su capacidad eyaculatoria y los resultados... Lubrificar Saliva, gel lubrificante, leche hidratante... Elige el que quieras y lubrica el pene para que la masturbación se parezca lo máximo posible a la sensación que tiene en la penetración. Este aspecto es todavía mas importante para los que están circuncisos: sin lubricante se corre el riesgo de irritación. Técnica Coloca la mano alrededor del pene en erección. Sujétalo bien pero sin apretar demasiado. Acarícialo realizando movimiento de arriba a abajo buscando el ritmo y la presión que más placer le aporten a él. No dudes en estimular los testículos al mismo tiempo: a algunos les encanta. ¿La excitación va aumentando y notas? Acelera los movimientos si quieres que termine rápido o ralentiza para prolongar el placer. Tras la eyaculación cesa la estimulación ya que el pene se queda muy sensible. Tipos de masturbación Cierto es que el término no es muy bonito... pero su práctica tiene el don de excitar hasta el punto más álgido. Desde los preliminares hasta el orgasmo: - Una cubana: el hombre coloca el pene entre los senos y lo mueve hacia delante y hacia atrás. Consejo: acerca los senos lo máximo posible para apretar bien el pene. - Un griego: sin penetración, el hombre desliza su pene por las nalgas de su pareja. - Un tailandés: el hombre coloca los pies de la mujer alrededor de su pene y mueve su pelvis. No es la práctica más eficaz pero los fetichistas la aprecian mucho. Opinen con respeto, no se precipiten en sus comentarios...

Una linda y fuerte relación amorosa es lo que la mayoría anhela, pero para muchos es algo difícil de alcanzar. Así lo afirma la doctora en psicología y experta en relaciones de pareja, Margaret Paul, quien señala que existen algunas razones por las que algunas personas no consiguen ser amadas como quisieran. 1. Te abandonas a ti mismo/a La experta dice que te abandonas a ti mismo cuando: Permaneces enfocado en tu cabeza en lugar de tener presentes tus sentimientos; te juzgas duramente, poniendo un montón de presión en ti mismo/a; caes en vicios (drogas, alcohol u otros) para evitar tus sentimientos y llenar tu vacío interior; y responsabilizas a otras personas de tu felicidad y autoestima. “Las personas que se aman y valoran a sí mismas y que se responsabilizan de su propia felicidad y autoestima, no se sienten atraídas por personas que se abandonan a sí mismas”, señala la especialista, añadiendo que es común que dos personas que se abandonan a sí mismas se junten y esperen que sea el otro quien les de el amor que ellos no se dan a sí mismos. Finalmente al no recibir lo que quieren, se decepcionan. En definitiva, la especialista dice que es prácticamente imposible “dar amor” a otra persona cuando no nos amamos a nosotros mismos. 2. Tienes miedo al rechazo Cuando te abandonas te estás rechazando a ti mismo, por lo que naturalmente temes que otros te rechacen, dice Paul. “El miedo al rechazo lleva a una sensación de ansiedad en las relaciones, lo que lleva -a su vez- a tratar de tener el control de no ser rechazado”, indica la experta. “Hagas lo que hagas para controlar el hecho de no ser rechazado (ser demasiado agradable, tener relaciones sexuales antes de tiempo, ser complaciente, tolerar el comportamiento falto de amor por parte de la otra persona) no es auténtico y, suele conducir al rechazo que estás tratando de evitar”, añade la psicóloga. 3. Miedo a ser consumido por la relación Como tienes padres controladores aprendes que debes entregarte completamente para evitar ser rechazado y tal vez tengas un gran miedo a ser consumido por una relación, dice la experta. “Puedes pensar que necesitas entregarte por completo para ser amado y evitar el rechazo”, dice la experta, por lo que podrías comenzar a “retirarte” cuando sientes que eso es lo que pasará. “Si te encuentras fuerte en el comienzo de una relación y luego pierdes el interés en cuanto la otra persona está interesada, entonces es probable que tengas miedo a ser consumido” indica Paul. 4. Tu nivel de Felicidad y Autoestima “Si eres una persona infeliz con baja autoestima, ¿se puede esperar que una persona feliz con autoestima alta se sienta atraída por ti? Es muy poco probable”, señala Paul. La terapeuta asegura que “el problema es que es posible que tampoco te sientas atraído por otra persona infeliz. Es probable que tengas la esperanza de encontrar una persona feliz que te haga feliz, pero por lo general no funciona de esta manera”. “Si deseas atraer a una persona feliz y tener una relación de amor verdadero, entonces tienes que hacer primero un trabajo interior para convertirte en una persona feliz”, explica. 5. Te apegas al resultado Paul dice que cuando conoces a alguien y te apegas a los resultados -es decir, que logre tu felicidad y valga la pena que te guste- puedes distanciar a la otra persona. “La mayoría de nosotros no quiere ser responsable de la felicidad, valor y bienestar del otro. No es amor cuando alguien se enfoca en conseguir el amor y no en amar”, indica. ¿Cómo atraer el amor? “¿Tu intención primaria en una relación es conseguir amor o compartir tu amor con tu amado?” pregunta Magaret Paul. Ella dice que si es conseguir amor, entonces tu desafío es aprender a amarte a ti mismo y compartir tu amor. “Si quieres estar en una relación de amor comprometido y no has sido capaz de manifestar esto en tu vida, o si tu relación actual no está funcionando, entonces primero debes aprender a crear una relación de amor contigo mismo”, señala la terapeuta, indicando que una vez que aprendas esto, encontrarás que es mucho más fácil atraer el amor y tener la relación feliz que deseas.
Detectan potencial sustancia cancerígena en alimentos. Primer estudio de furano en el país alerta de su presencia en productos como café y colados. El furano es un compuesto tóxico que estudios han demostrado que provoca cáncer en animales. La sustancia puede aparecer en la producción de alimentos procesados a altas temperaturas. Incluso, aunque aún no hay evidencia concluyente, la Agencia Internacional de Investigación sobre el Cáncer dependiente de la ONU lo incluyó como posible carcinógeno en humanos. Ahora, un estudio del Departamento de Ingeniería Química y Bioprocesos de la U. Católica demostró que la sustancia está presente en un gran número de alimentos procesados que se venden en el país . Se trata de la primera investigación en el país sobre este compuesto potencialmente cancerígeno para humanos y que no cuenta con regulación nacional ni mundial. El furano es una sustancia que se encuentra en alimentos tratados térmicamente como las conservas y alimentos para bebé. También está presente en alimentos procesados a altas temperaturas como pan tostado y galletas. Además, es un componente normal del café de máquina. “El furano está recibiendo considerable atención debido al hecho de que este contaminante inducido por el calentamiento se considera como posible cancerígeno. Los actuales niveles de exposición de los humanos al compuesto podrían representar un riesgo para la salud”, dice María Salomé Mariotti, autora principal del estudio, una de las científicas chilenas que en 2012 recibió el premio L’Oréal Chile-Unesco “For Women in Science”, que resalta a las investigadoras más destacadas. RESULTADOS: En el estudio, desarrollado junto a expertos del Departamento de Nutrición, Diabetes y Metabolismo de la UC y del Instituto Nacional de Alimentos de la U. Técnica de Dinamarca, se analizaron 14 tipos de alimentos de todas las marcas disponibles en el mercado, entre los que se encuentran la salsa de tomates, jugo de naranja, durazno en conserva, alimentos para bebés, peras en conserva, mermelada de damasco, café, papa fritas, galleta de soda, pan tostado, cereales para el desayuno y carne frita. La investigación cruzó datos del consumo de alimentos de diferentes sectores etarios con las cantidades de furano en determinados alimentos y en base a ello se estimó la ingesta diaria dietaria de furano por peso corporal. El estudio demostró que los niños en edad escolar son los más expuestos en su dieta diaria a este componente, a través del consumo de los chips de papas fritas; le siguen los bebés, que lo reciben en los colados; y luego, los adultos y ancianos, vía la ingesta de galletas de agua. (ver infografía) “Para mitigar el impacto del furano se deben hacer recomendaciones tanto a la industria como a los consumidores para tomar conciencia de la ingesta de este contaminante químico y reducir lo más que se pueda su exposición”, señala Franco Pedreschi, otro de los autores del estudio, quien detalla que la investigación se desarrolló entre 2012 y 2013. Asimismo, plantea que las empresas productoras de alimentos tienen un desafío en implementar tecnologías y emplear materias primas que permitan disminuir el contenido de furano en alimentos procesados térmicamente sin afectar en forma significativa sus atributos sensoriales al consumidor”, recomienda Pedreschi, quien además investiga otro compuesto tóxico, la acrilamida (ver recuadro). NO HAY NORMA EN CHILE: Paulina Chávez, experta del Departamento Alimentos y Nutrición del Ministerio de Salud, señala que efectivamente no hay norma sobre estos componentes en el país. “Respecto a furano y acrilamida en alimentos, no existe regulación nacional al respecto, no se han establecido contenidos máximos en los alimentos”. Sin embargo, la experta señala que tampoco existe normativa al respecto en la Unión Europea ni en Estados Unidos, “como tampoco el Codex Alimentarius, nuestro referente normativo internacional en materia alimentaria”. RESPUESTA DE LA INDUSTRIA: La Asociación de Alimentos y Bebidas de Chile (ABChile), señala que el furano es un componente orgánico que se forma en bajas cantidades como subproducto natural en los alimentos durante su calentamiento o cocción, y se encuentra presente en una amplia variedad de alimentos. "Cada vez que un alimento es cocinado o calentado, ya sea a nivel industrial o doméstico, se puede generar esta sustancia que ha estado presente desde que el hombre comenzó a cocinar”, afirman. Asimismo, indican que ninguno de los organismos internacionales que son referentes normativos para Chile en materia alimentaria, han establecido recomendación alguna sobre su consumo. Pese a ello, sostienen que realizaran todos sus esfuerzos por “incorporar los últimos avances científicos en cuanto asegurar la salud y la correcta nutrición de nuestros consumidores”. ¿Qué es el furano?: Este compuesto orgánico es altamente volátil y pueden formarse de manera no intencional en los alimentos durante el procesamiento a partir de precursores que son componentes naturales de los alimentos, clasificándose como contaminantes de los alimentos. ¿Que ocurre en el resto del mundo?: Achipia aclara que actualmente no existe regulación nacional al respecto, ni se han establecido contenidos máximos en los alimentos. Tampoco existe normativa al respecto en la Unión Europea ni en Estados Unidos, como tampoco el Codex Alimentarius, referente normativo internacional en materia alimentaria. Agrega que "estudios en animales han demostrado que furano es carcinogénico en ratas y ratones. Sin embargo, no está claro que estos resultados puedan extrapolarse al ser humano, por lo que la International Agency for Research on Cancer (IARC) lo ha clasificado como posible carcinogénico para humanos". La entidad dijo que "en 2004, la Food and Drug Administration (FDA) publicó un reporte de la presencia de furano en alimentos procesados térmicamente, el cual reveló la existencia de este compuesto en alimentos como enlatados y conservas". El organismo del ministerio de Agricultura añadió que "en Chile, se han desarrollado estudios de investigación por parte de la academia, en los cuales se ha medido la presencia de este compuesto en los alimentos de riesgo con el fin de determinar la exposición dietaria en diferentes grupos etarios. Además, al igual que el caso de acrilamidas, se está investigando la forma de disminuir la formación de este compuesto en los alimentos implicados".
5 preocupantes suposiciones de los jóvenes sobre el sexo anal. Sería un error aún más grave considerar el sexo anal como una práctica exclusiva de homosexuales. Según un estudio publicado recientemente por la Escuela de Londres en Higiene y Medicina Tropical en la revista científica BMJ Open, 1 de cada 5 adolescentes entre 16 y 18 años -hombres y mujeres- lo han practicado en los albores de su sexualidad. Sin embargo lo preocupante son los conceptos que los jóvenes tienen del mismo, precisamente a causa de la falta de información. 1. “Doloroso, riesgoso y coercitivo, sobre todo para las mujeres” Con estas palabras, la institución resumió el concepto general que tienen los jóvenes sobre el sexo anal, una situación que debiera alarmarnos considerando que esta práctica está en auge, al compararla con estudios anteriores similares. “El sexo anal es cada vez más prevaleciente entre la juventud. Esto pese a que la penetración anal entre hombres y mujeres -aún apareciendo con frecuencia en medios explícitos- está usualmente ausente de los planes de educación sexual y es un tema prohibido en la mayoría de los contextos sociales”, advierten los investigadores. “Que muchos jóvenes asimilen como normal que esta práctica sea forzada, dolorosa y arriesgada es algo que deben comenzar a combatir los trabajadores de la salud y las escuelas en sus planes de educación sexual”, recoge el diario británico The Independent. Como muestra de lo anterior, la líder de la investigación, doctora Cicely Marston, informó que de las mujeres entrevistadas, sólo una afirmó que el sexo anal había sido una experiencia placentera para ella. 2. Favorable a los hombres, perjudicial para las mujeres En las respuestas entregadas por los 130 adolescentes entrevistados, quedó claro que si bien el sexo anal se da regularmente en el contexto de parejas estables, rara vez ocurre como una forma de exploración o placer sexual mutuo. Muy por el contrario, los hombres ven el sexo anal como una competencia donde quien logra hacerlo con más chicas aumenta su prestigio ante sus pares, mientras que -por el contrario- las mujeres que acceden ven afectada su reputación. Esto, aunque varios de los hombres entrevistados aseguraron que la experiencia no les resultó tan placentera como habían imaginado. 3. Las mujeres son fuertemente presionadas a practicarlo Aún más preocupante que lo anterior, es que en la mayoría de los casos las mujeres son presionadas de forma persistente para practicarlo, pese a que tanto el hombre como la mujer tienen el concepto de que será una experiencia dolorosa para ellas. “Que la mujer sea empujada casi a la fuerza a tener sexo anal es visto como algo normal entre los jóvenes”, indica el estudio. “Para las mujeres es algo corriente estar en una situación donde debe aceptar de mala gana u oponerse a su compañero, en vez de ser iguales en el ámbito de las decisiones que toman para su vida sexual. Ser capaz de decir que no era frecuentemente citado por las mujeres como un ejemplo positivo de controlar la situación”, añade. 4. “Accidentes” que colindan con la violación En muchos de los casos encuestados, la práctica de sexo anal se inició de forma no consensuada, con el hombre intentando penetrar a la mujer con su dedo o su pene esperando que esta no presentara oposición. “Algunos eventos, particularmente la penetración ‘accidental’ reportada por algunos entrevistados, eran demasiado ambiguos como para saber si podían calificarse como una violación. Uno de los jóvenes nos aseguró que le había dicho a su novia que la había penetrado accidentalmente, cuando en realidad lo había hecho a propósito”, indica la Escuela de Londres. 5. Desconocimiento sobre contraer enfermedades o provocar un embarazo Quizá uno de los puntos más preocupantes que develó el estudio, es el mito generalizado entre los jóvenes respecto de que a través del sexo anal no se contraer enfermedades de transmisión sexual. De hecho, muchos de ellos aseguraron que usaban preservativo sólo como una medida de higiene personal, no de protección. De igual forma se demostró extendida la creencia de que el sexo anal es un método anticonceptivo, cuando en realidad la cercanía de la cavidad del ano y la vagina en las mujeres puede provocar que el semen se traslade de una a otra, provocando un embarazo. Finalmente, la doctora Marston urgió a los organismos competentes a abordar el sexo anal como parte de los programas de educación sexual. “Existe una necesidad urgente de realizar esfuerzos paliativos hacia el sexo anal y a animar la discusión en torno a la relación de pareja y el consentimiento, a reducir las técnicas dolorosas o arriesgadas, y a cambiar los puntos de vista que institucionalizan la coerción”, señaló.
El Trauco es un ser legendario con las características de un Incubo o demonio masculino que seduce mujeres humanas, es parte de muchas historias en la mitología Chilota o de los habitantes de Chiloé (sur de Chile). Se dice que pudo ser un ángel quien cayó ante la lujuria de poseer mujeres humanas y que Dios lo condeno por este acto maldiciéndole y deformándole hasta ser un ser espantoso, pero aun con este defecto sus ansias por las jóvenes no se ha calmado nunca. También se dice si nos adentramos más en la mitología de Chiloé que sería un hijo bastardo de la serpiente mítica Caicai nacido de la pura rabia q tiene con los humanos y de la ingratitud que algunos hombres tienen con el mar a pesar de sus bondades. El Trauco vive con su hija que ahora es su esposa Fiura nacida de una relación que tuvo con la Condená un ser femenino maligno que fue maldecido por la mala vida que tenía. Tienen varios hijos que tienen su apariencia del Trauco como de Fiura respectivamente si son hombres o mujeres. El Trauco vive en el bosque junto a su esposa dentro de algún hueco en un árbol o en cavernas pequeñas alimentándose solo de naranjitas el fruto de la Quilineja. Las historias del Trauco son muchas pues su apetito por las mujeres humanas que son vírgenes es insaciable y su infidelidad legendaria, siempre buscando jovencitas solas en el bosque colgado en alguna rama de un árbol esperando su oportunidad. Una vez que encuentra alguna con su hacha mágica que derriba arboles al tercer golpetazo las va perdiendo hasta que desorientadas no pueden huir de él. Su mirada es paralizante, le soplara su aliento que la dejara enamorada a pesar de su horrible forma, ya no podrá alejarse de él, le seguirá hasta lo más profundo del bosque donde este saciara sus más bajos apetitos; cuando estas vuelven se les ve las marcas de ese encuentro, en golpes, moretones y heridas en especial el rostro de la chica, muchas quedan embarazadas por este encuentro. Cuando el Trauco está interesado en alguna joven que está muy cuidada o no sale de su casa, este intentara por los sueños comunicarse con ella, enviándole sueños libidinosos donde ella esta con el hombre de sus sueños. Así poco a poco va abriéndose paso en el carácter de la joven hasta que el por alguna puerta o ventana abierta entrara y con su magia aparentara ser el hombre con quien ella sueña, también puede entrar oculto entre el carbón o leña que se lleva al casa adoptando la forma de un manojo de quilineja, ya en la noche mientras todos duermes iría hasta la habitación de la joven y consumaría su malvado acto. Pero el Trauco siempre lo hace furtivamente sin testigos, si alguien se cruza en sus asuntos en el momento puede hechizar con la mirada o con su aliento a la persona dándole diferentes síntomas desde deformaciones, torceduras en sus miembros, epilepsia hasta la muerte, por eso cuando la familia sospecha que su hija podría estar en problemas, tiene medios para prevenir y espantar al Trauco: Pueden poner en la mesa arena seca antes de dormir, pues el Trauco siente un deseo por contar los granos de arena hasta el amanecer donde huye y así deja pasar la oportunidad; Otra forma es dejar sobre la joven excrementos ya que esto asquearía al Trauco que siente repugnancia por este acto y la dejaría de codiciar; Hacer cruces con cuchillos y dejarlo en diferentes lugares de la casa, esto aleja la presencia del Trauco; Poner cenizas en las cuatro esquinas de la casa esto también aleja al Trauco. El Trauco tiene facciones desagradables, asemejándose a una persona de baja estatura no más de 90 centímetros, sus piernas sin pies solo tienen muñones terminando en los tobillos. Posee un bastón retorcido llamado Pahueldún y un hacha mágica de piedra la cual puede cortar cualquier árbol en el tercer golpe, viste un sombrero cónico que como el resto de su ropa está hecha de quinileja una planta del lugar.

EL CALEUCHE: El nombre de “Caleuche”, es muy discutido en su origen; voy a inclinarme por la derivación caleutun=cambiar de condición y che=gente, posiblemente elegido, para referirse a los cambios de muertos a vivos, de afligidos a dichosos o a las muchas transformaciones que puede experimentar el barco, etc. El Caleuche es el buque fantasma que recorre los mares y aparece, con relativa frecuencia, en los canales chilotes. Navega tanto en la superficie, como en las profundidades; pero jamás lo hace a plena luz del día. En las noches tranquilas, suele aparecer entre la niebla, mostrando las características de un gran buque velero. Profusa iluminación multicolor de brillo extraordinario, realza su presencia. A la distancia, es posible apreciar en su cubierta, bullanguera agitación y desde su interior vienen armoniosos acordes de flautas, cuernos, pitos y tambores y de muchos instrumentos desconocidos. Con la misma velocidad que hizo su aparición, desaparece borrado por la espesa niebla, que fluye abundante desde sus costados y que al desvanecerse, casi instantáneamente, no deja huella alguna de la impresionante visión. Cuando es perseguido por curiosos, malintencionados, suele transformarse en una escurridiza foca o en un gran tronco de árbol, especialmente de ciprés, que navega entre dos aguas o que se recuesta en las tibias arenas de la playa. La tripulación del Caleuche, está integrada por dos clases de navegantes: unos son los brujos, que llegan desde tierra montados sobre el lomo de un “Caballo Marino”. Los otros, son los náufragos, cuyos cadáveres trajo abordo la Pincoya y que al instante mismo de poner pie en cubierta, retornan a la vida; pero ahora, a una vida nueva de felicidad eterna. Estos dichosos marineros, a pesar de pertenecer al más allá, obtienen permiso de sus jefes una vez al año, para hacer breves visitas a sus familiares, que lloran su muerte; llevándoles consuelo y aún ayuda económica. Aunque, en algunas ocasiones, sus visitas se ven frustradas y no vuelven a repetirlas jamás; esto suele ocurrir a los difuntos maridos, que regresan a calmar las angustias de las inconsolables viudas que dejaron tan solas; pero que se encuentran muy dichosas, en los brazos de otros hombres. Cada cierto tiempo, la tripulación del Caleuche, sale a tierra a divertirse, en casa de gente amiga o de algún individuo, a quien se le ha impuesto la obligación de festejarlos, con sus propios recursos, como castigo, por haber cometido un acto calificado por ellos delictuoso. Es lo que le ocurrió a un tal José Huala, habitante de la localidad de Coñab, quien en una oportunidad, usó explosivos para pescar en el mar; por este hecho, debió festejar hasta el fin de sus días a los navegantes del Caleuche. Estos enormes gastos extraordinarios, ocasionaron al infortunado Huala, gran pobreza. Una vez terminada la fiesta terrestre, siempre abundante en libaciones y comidas y antes del amanecer, regresan los alegres caluchanos, a su barco invisible y elevan anclas, produciendo sonoro ruido de cadenas, que siempre es oído por varios vecinos, quienes saben que provienen del “Buque de Arte”, que acostumbra a fondear, frente a la casa de Fulano y a esta amistad o enemistad, se debe la prosperidad o la miseria económica del vecino en cuestión. El Caleuche tiene como misión muy especial, recorrer todos los mares y es natural, que no escape a los mandatos del Millalobo, dueño y señor de ellos. El objetivo de estos viajes, consiste en conocer el estado en que se encuentran los seres que en ellos habitan; marcar los animales de nueva generación y protegerlos en su desarrollo. Que esta inspección es severa, se refleja en el caso ocurrido a Pancho Calhuante, de la aldea de Matao: una noche, mientras se encontraba pescando en las cercanías de un roquerío, divisó a una loba que amamantaba a su pequeñuelo; se acercó sigiloso y con un remo, golpeó brutalmente a ambos, dando muerte al lobezco, que llevó a su casa para aprovechar el aceite. Frente a la puerta d esa casa y a cierta distancia en el mar, la loba lloraba la pérdida de su hijo. Al cuarto día de transcurridos los hechos anotados, tres hombres vestidos de marinos, que dijeron pertenecer a la dotación del Caleuche, se presentaron, de improviso, en la casa de Calhuante, para manifestarle que la muerte que ocasionó al lobezno, la pagaría con la muerte de su hijo mayor, el que efectivamente falleció a los pocos días. Durante su recorrido por los mares, el Caleuche suele ayudar a las naves amigas a sortear las tempestades, conduciéndolas presuroso a puertos seguros, o remolcándolas a velocidades, que según los relatores, no admiten otra explicación. Esta interesante y compleja leyenda, cuyo origen podemos tal vez encontrar en los fenómenos de espejismo, etc., se presta a múltiples interpretaciones y desde diversos ángulos. Voy a comentar brevemente, sólo aquello que se relaciona con los náufragos. Las garantías de que gozan los náufragos recogidos por el Caleuche, podrían corresponder a ciertas formas de estímulo, para los hombres de mar, con el objeto que pierdan el temor innato a sus aguas profundas y traidoras. La venida, desde el más allá, una vez al año de los que creíamos muertos y desaparecidos, trayendo consuelo y riquezas, podríamos relacionarla con los fenómenos de fecundación de animales y plantas y la recolección anual de sus frutos. Todos los pueblos, tienen en sus creencias míticas, un lugar destinado a llegar, más allá de la muerte; probablemente como un gran consuelo al temor de desaparecer para siempre. Es de imaginar que los pueblos marineros y entre ellos los chilotes, hayan deseado la cubierta de un barco, el sitio ideal, para perpetuar su vida más allá de la muerte. El cielo de los cristianos, el nirvana de los budistas, el algo sagrado de los egipcios, etc., tendrían, por tanto, su equivalente en el Caleuche. La vida que aparentemente desaparece con la muerte, siempre retorna; a una inferior, con los despojos materiales a una vida mejor y superior, con los esfuerzos logrados por la mente y que la muerte no puede destruir.

Caí Caí-Vilu y Ten Ten-Vilu. La leyenda cuenta que hace miles de años Chiloé formaba parte del continente.Un día apareció el espíritu de las aguas , en forma de culebra ; Cai Cai Vilu. El espíritu estaba enojada con los hombres que habitaban la tierra y quería destruirlas.Cai Cai Vilu ordeno el ascenso de las aguas para que se ahogaran las personas que allí vivían , ocasionando con ella la inundación de las tierras bajas , valles y colinas. Pero fueron muchos las que lograron huir a las cerras mas altas para que lograr el agua no las alcanzara.los habitantes ,al ver lo que ocurría con aquel espíritu , desesperados clamaron por la presencia del gran espíritu protector ,que era el único que podría hacer algo para salvarlas de tanto peligro.Una noche de luna , elevaron canticos y promesas, suplicas y lamentos. Las suplicas de estas personas buenas y trabajadoras , que pedían por su salvación , lograron despertar a Ten Ten Vilu, quien dormía en sus entrañas de la tierra ,y quien no dudo en ir en su ayuda .Cuando las aguas cubrían gran parte de la tierra , se presento este espíritu protector –Ten Ten Vilu- también en forma de culebra , originado con su presencia el inicio de una larga batalla ,ya que ambas culebras se enfrentaron en un gran duelo . La lucha entre estas dos fuerzas contrarias el bien y el mal fue ardua y penosa. Golpeaban sus colas con gran violencia, lo que provocaba terribles temblores que afectan al os habitantes de la tierra.Muchos de ellos, sin poder encontrar de donde agarrarse, pues el aliento de estas dos culebras provocaba grandes tornados de viento, que arrasaban , en algunos lugares ,toda la vegetación ,caían alas aguas que cubrían los valles .Ten Ven Vilu , para tratar de salvar a los pobladores que caían a las aguas , los transformaba en hermosos peces o en piedras , y como Cai Cai Vilu , con mucha furia. Trataba de elevar cada vez el nivel de las aguas, ten ten vilu hacia subir el nivel de las tierras casi hasta la altura del sol para impedir así que los hombres murieran ahogados.Después de largos años de batalla, durante las cuales de las dos fuerzas enemigas demostraba clara supremacía, Ten Ten Vilu, muy cansado ,logro , sin embargo, vencer a su adversario clavándole sus afiladas colmillos en la cabeza . Pero Cai Cai Vilu ,furioso al verse derrotado , antes de hundirse en el mar levanto su gran cola y golpeo la tierra ,haciendo que estas partiera en decenas de pedazos que quedaron flotando sobre las tranquilas aguas . Lo que había sido el campo de batalla de las dos culebras nunca mas recupero sus antiguos limites , ya que lo valles quedaron para siempre convertidos en un gran golfo y los cerros en islas.Antes de que ten ten vilu regresara alas profundidades de la tierra ,trato de transformar a los peces y piedras que estaban en el fondo del mar nuevamente en seres humanos ,pero no lo logro. De todas maneras, les hizo la promesa de que siempre los protegería. Opción 1: link: http://www.youtube.com/watch?v=NZ04kH5IXcQ#t=12 Opción 2, Musicalizada: link: http://www.youtube.com/watch?v=L-RWHIiKbr0

Pedro Urdemales, el mentiroso por tradición. Pedro Urdemales es un personaje de la mitología popular de Latinoamérica -especialmente Chile- que tipifica al pícaro, pillo o burlador de carácter campestre. Esta basado en el personaje mítico español del medioevo Pedro de Urdemalas. Pedro Urdemales engaña al diablo. En una ocasión el diablo trabajó una noche entera limpiando una hectárea de pampa. Sacó todos los troncos y emparejé la tierra. A la mañana siguiente decidió sembrar papas en sociedad con Pedro Urdemales. Pasó el tiempo y llegó la época de la cosecha. — Señor Diablo —dijo Pedro—, como vamos a medias, le propongo que todo lo que esté arriba sea suyo y lo que esté bajo la tierra sea mío. — Acepto —contesté de inmediato el Malo. Ambos trabajaron intensamente. Y una vez que Pedro terminó la cosecha, para celebrar este acontecimiento preparé unos deliciosos milcaos. En eso estaba cuando llegó el Diablo. — ¿Qué estás haciendo, Pedrito? — Unos ricos milcaos. El Diablo observó todo el proceso de elaboración de los milcaos: el rallado de las papas, el amasado y cómo los enterraba en la ceniza caliente para que se cocieran. Cuando el Diablo probé los milcaos no pudo evitar una exclamación de elogio: — ¡ Puchas que están buenos! Yo también haré en mi casa. Allí intentó asar las hojas de las papas en las cenizas. Cuando las fue a ver se habían transformado en carbón. Al otro día, el Diablo se encontró con Pedro: — Me engañaste —fueron sus primeras palabras—. Ahora —agregó— haremos otra sociedad; sembraremos trigo. El tiempo pasó rápido y de nuevo llegó el momento de cosechar. — Ahora —dijo el astuto Pedro al Diablo—, la parte de arriba será la mía y la de abajo la tuya. — Acepto —exclamó el Diablo. Terminada la cosecha, Pedro Urdemales se quedó con los granos de trigo y el Malo con las cañas. Pronto éste visitó la casa de Pedro y vio cómo preparaba una deliciosa chuchoca. Cuando el Malo la probó, expresó su agrado por tan deliciosa comida. Partió raudo a su casa para hacer lo mismo con las cañas cosechadas por él. Apenas las puso al fuego ardieron rápidamente, perdiendo de nuevo todo lo cosechado. — Puchas —exclamó—, otra vez este Pedro Urde-males me engañó. El enojo del Diablo ya no tenía límites. Estaba decidido a tomar venganza. Se hizo una reflexión. — Este Pedro me ganó las dos apuestas eligiendo, primero, lo de abajo y, después, lo de arriba. Ahora le propondré que se quede con lo del medio. Pronto conversó, una vez mas, con Pedro y de nuevo le propuso sembrar a medias, colocando una condición: — Ahora, pues, Pedrito, tú te quedas con la parte del medio. — Bueno, don Sata—replicó el astuto Urdemales—, acepto esa condición. Esta vez sembraremos maíz. El Diablo quedó muy satisfecho, con la seguridad de alcanzar, en esta ocasión, el triunfo. Al llegar el tiempo de la cosecha Pedro se quedó con los choclos, que estaban al medio de la planta, y el Malo con las raíces y las hojas. Grande fue la furia del Diablo al percatarse de que, una vez más, había sido engañado y derrotado. — Puchas —exclamó—, me ha vuelto a ganar. Totalmente enojado, le dijo a Pedro: — Haremos la última apuesta, pelearemos a uña. — Ahora sí que me vas a ganar —expresó Pedro Urdemales—. Tú tienes una uña muy larga y la mía es muy pequeña. A la mañana siguiente, antes del desafío, Pedro visitó a una viejita que tenía una inmensa y profunda cicatriz en el rostro. Conversó con ella y le pidió que cuando pasara el Diablo le dijera que Pedro Urdemales le había hecho el corte en la cara. — ¡Listo no más! —le dijo ella—. Haré lo que me pides. Cuando el Diablo pasó frente a su ventana le hizo un comentario: — Hoy tengo una pelea a uña con Pedro. — Señor Diablo, no lo haga. Mire cómo ese bandido de Pedro Urdemales dejó mi rostro con su uña. Grande fue el susto que dominó a Satanás al ver la profunda cicatriz de la anciana. — Entonces no —exclamó el Malo-. No, no voy a pelear. De un solo uñazo capaz que Pedro me destripe. Hecha esta reflexión, el Diablo se alejó rápidamente, evitando cumplir el desafio con Pedro Urdemales.